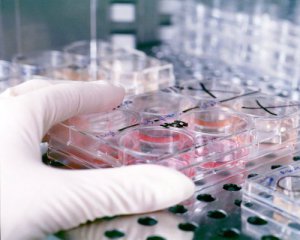

Чим більше розвивається клонування, тим більше хвороб зможе перемагати людство, каже провідний науковець Китайської академії наук Кін Сан.
Протягом останніх 20 років учені успішно клонували більше трьох десятків тварин. Це були коти й собаки.
Досі успішно клонувати приматів не вдавалося. Народжувалися близнюки, а не ідентичні копії. Макаки Чжон Чжон і Хуа Хуа зачали методом перенесення ядра із соматичної клітини в позбавлену власного ядра яйцеклітину. Це - новий ривок у світовій науці.
Часто клонування практикують при пересадці органів від тварини до людини.
"Можливе створення органів чи тканин людини з її власних клітин. Клонування може допомогти людям, яким потрібна пересадка органів. Їх можна вирощувати у свинях. Ця тварина найближча до людей за формою і розміром печінки та серця. Такий генетичний матеріал краще підходить для трансплантації, бо чужі органи організм може відторгати", - розповідає Gazeta.ua завідувач відділу генетики клітинних популяцій Інституту молекулярної біології і генетики НАН України Віктор Кунах.
Клонування тварин дає більш повну картину процесів розвитку ембріона. Генетично ідентичні тварини можуть допомогти в дослідженні людських хвороб. До прикладу, можна створити моделі генетично обумовлених захворювань людини, які необхідні для дослідження механізмів розвитку захворювання і тестування ліків.
ЧИТАЙТЕ ТАКОЖ: Чи клонують людину - думки науковців
Китайські дослідники вважають використання мавп перспективним для дослідів, що стосуються лікування хвороб головного мозку. Зараз такі дослідження проводять на мишах та щурах. Але примати генетично і фізіологічно ближчі до людини. Тому проведені на мавпах досліди будуть більш точними та даватимуть кращі результати.
Китайські науковці першими клонували мавп. Самок макак назввали Чжон Чжон і Хуа Хуа. Старшій - 8 тижнів. Молодшій - 6 тижнів. Генетики вдосконалили метод, який застосовували для клонування знаменитої овечки Доллі 22 роки тому. Цей метод більше 20 років повторювали на інших тваринах. Проте ці спроби були невдалими.
Коментарі